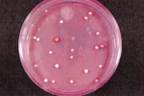
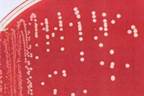
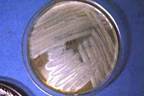
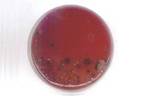
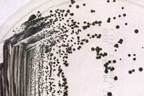
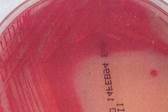

КАТЕГОРИИ:
Архитектура-(3434)Астрономия-(809)Биология-(7483)Биотехнологии-(1457)Военное дело-(14632)Высокие технологии-(1363)География-(913)Геология-(1438)Государство-(451)Демография-(1065)Дом-(47672)Журналистика и СМИ-(912)Изобретательство-(14524)Иностранные языки-(4268)Информатика-(17799)Искусство-(1338)История-(13644)Компьютеры-(11121)Косметика-(55)Кулинария-(373)Культура-(8427)Лингвистика-(374)Литература-(1642)Маркетинг-(23702)Математика-(16968)Машиностроение-(1700)Медицина-(12668)Менеджмент-(24684)Механика-(15423)Науковедение-(506)Образование-(11852)Охрана труда-(3308)Педагогика-(5571)Полиграфия-(1312)Политика-(7869)Право-(5454)Приборостроение-(1369)Программирование-(2801)Производство-(97182)Промышленность-(8706)Психология-(18388)Религия-(3217)Связь-(10668)Сельское хозяйство-(299)Социология-(6455)Спорт-(42831)Строительство-(4793)Торговля-(5050)Транспорт-(2929)Туризм-(1568)Физика-(3942)Философия-(17015)Финансы-(26596)Химия-(22929)Экология-(12095)Экономика-(9961)Электроника-(8441)Электротехника-(4623)Энергетика-(12629)Юриспруденция-(1492)Ядерная техника-(1748)
Деменции
|
|
|
|
Схема репродукции вируса гепатита В.
Схема репродукции вируса иммунодефицита человека.
Схема репродукции вируса гриппа.
Схема строения вируса гриппа.
Схема репродукции вируса гепатита В.
Схема репродукции вируса иммунодефицита человека.
Схема репродукции вируса гриппа.
Схема строения вируса гриппа.
IV. При отсутствии необходимого лечения болезнь переходит в следующую стадию - терминальную или декомпенсации - эта стадия является необратимой, т.к. погибшие нефроны не способны к регенерации. Она сопровождается олигурией, анурией, уремией и уремической комой.
Патогенез почечной гипертонии. Работами многих ученых установлено, что развитие нефрогенной гипертонии обусловлено повышенным выделением в кровь протеолитического фермента - ренина, который вырабатывается гранулированными клетками юкстагломеруллярного аппарата в ответ на гипоксию почечной паренхимы. Причиной гипоксии является:
1) нарушение артериального притока крови к почкам или
2) прогрессирующие разрастание соединительной ткани и
3) облитерация сосудов.
Ренин запускает антиотензиновую систему - от ангиотензиногена отщепляет декапептид - ангиотензин-I, из которого под влиянием специального "превращающего" фермента (дипептидкарбоксипептидазы) образуется октапептид ангиотензин-II - самый сильный из всех естественных вазоконструкторов. Механиззм действия ангиотензина-II показан в опытах Фридмана - установлено, что если в стеклянный сосуд с раствором натрия и калия поместить часть артериолы и добавить ангиотензин-II, то это приводит к вхождению в стенку сосуда ионов натрия и выходу из стенки калия - т.е. совершается обычный Na/K насос. Вхождение в стенку сосуда ионов натрия
1) повышает тонус сосуда и ведет к повышению АД (возбудимость, биопотенциал). При этом 70-75% составляет миогенный компонент и 25-30% нейрогенный. Кроме того, при увеличении концентрации ангиотензина-II;
2) усиливается выработка альдостерона, который так же усиливает вхождение ионов натрия в сосудистую стену, повышает тонус сосудов и давление в клубочках почки.
Патогенез почечной анемии - при ХПН играют роль:
1) недостаток выработки в почках эритропоэтиногена,
2) появление в плазме больных ингибитора - вещества, которое угнетает эритропоэтин,
3) появление в крови факторов гемолизирующих эритроциты.
4) Под влиянием токсических веществ происходит угнетение костного мозга, нарушается нормальное развитие клеток красной крови > недостаток эритропоэза. Кроме токсических веществ эритропоэз угнетается в результате недостатка эритропоэтина < т.к. в результате поражения почек уменьшается выработка в почках эритрогенина, который в норме попадает в кровь и соединяется с эритропоэтиногеном, образующимся в почках и превращает его в эритропоэтин, который и стимулирует выработку эритроцитов.
Патогенез почечной геморрагии - понижение свертываемости крови при ПН обусловлено следующими механизмами:
1) тромбоцитопения в результате нарушения выработки тромбоцитов в КМ в следствии угнетения тромбоцитопоэза,
2) качественная неполноценность тромбоцитов - нарушение их способности к адгезии и игрегации,
3) снижение тромбопластической функции.
4) Поражение сосудов уремической интоксикацией > ломкость капилляров.
5) Повышение активности антикоагулянтов (гепарина и фибринолизина) - под влиянием мочевины и других азотистых веществ происходит угнетение дезаминирования гепарина и развивается гипергепаринемия. Этому способствуют:
1. избыточная продукция гепарина тучными клетками,
2. нарушение выведения гепарина пораженными почками,
3. замедление его инактивации гипариназой почек,
4. снижение антигепариновой активности крови.
Патогенез почечных отеков. При поражении почек могут возникать отеки:
1) нефротические (при нефрозах т.е. поражении канальцев) и
2) нефритические (при нефритах - поражении клубочков почек).
Патогенез отеков при нефрозах - поражение преимущественно канальцевого аппарата почек > увеличение проницаемости почечного фильтра для белков - альбуминурия > гипоальбуминемия > снижение онкотического давления крови > увеличение оттока воды в ткани - недостаточность обратного тока лимфы > уменьшение объема плазмы > гиповолемия > увеличение образования альдостерона и АДГ > задержка в организме натрия и воды > отеки по утрам на лице (особенно веки - где самая тонкая кожа).
Патогенез нефритических отеков связан с поражением клубочков - ведет к нарушению в них кровообращения, увеличению выработки ренина, который увеличивает образование ангиотензина-I и II, который активирует секрецию альдостерона. Альдостерон вызывает задержку натрия и воды? гипернатриемия - через осморецепторы активирует секрецию АДГ. АДГ активирует гиалуронидазу эпителия почечных и собирательных канальцев, разрушающую гиалуроновую кислоту стенки капилляров, повышая их проницаемость. Возникает генерализованный капаллярит - резко повышается обратная реабсорбация, вода задерживается в организме, а повышение проницаемости капилляров ведет к поступлению воды в ткани и возникновению отека. При этом в ткани выходит не только вода, но и белки плазмы крови. Поэтому отличительной чертой нефритических отеков является высокое содержание белка в межтканевой жидкости и повышение гидрофильности тканей. Отекам способствует также задержка натрия в тканях и повышение в них осмотического давления.
Изменения в организме при поражении почек. При различных поражениях почек возникает целый ряд нарушений функционального состояния различных органов и систем. Наибольшее значение имеют: гипертония, анемия, геморрагия, отеки и уремия.
Патогенез уремии - задержка в организме всех тех ядовитых продуктов (особенно белков) которые в норме выделяются из организма с мочой, т.е. в крови накапливаются составные части мочи: увеличение
1) остаточного азота крови с 20-40 мг% до 500-700 мг%,
2) мочевины с 15-25 мг% до 400-500 мг%,
3) мочевой кислоты с 2-4 мг% до 10-20 мг%,
4) креатина с 1-1.5 мг% до 30-35 мг%,
5) индикана с 0.001 мг% до 6-7 мг% (т.е. в 6000-7000 раз).
Происходит отравление организма и нарастающие явления интоксикации. Полагают, что отравление вызывается не самой мочевиной, а углекислым и карбаминовокислым аммонием. Поскольку мочевина в большом количестве выделяется в кишечнике, то под влиянием бактерий кишечника она превращается в токсическую форму углекислый и карбаминовокислый аммоний, который всасываясь из кишечника - отравляет организм. Большое значение в механизмах интоксикации при уремии имеет накопление в крови фенольных соединений: фенола, крезола, индолуксусной и других кислот.Что такое уремия - сложный симптомокомплекс явлений самоотравления организма продуктами азотистого обмена, мочевины, мочевой кислоты и других веществ, накапливающихся в организме. Это финал прекращения фильтрационной и концентрационной способности почек.
1. Интоксикация при уремии характеризуется определенными явлениями со стороны ЦСН: постоянные, упорные, резкие не прекращающиеся днем и ночью головные боли как следствие влияния токсических веществ, нарушение обмена кининов и возникновение отека мозга с определенными симптомами: сонливость, бред, галлюцинации, снижение слуха и зрения > потеря сознания - уремическая кома.
2. Раздражение продуктами азотистого обмена > упорные, очень мучительные рвоты (мучительные - центрального происхождения на пустой желудок на фоне отвращения к мясному и потери аппетита). При рвоте пустой желудок как бы выворачивает наизнанку, не принося облегчения. Развивается уремические гастрит, бронхит, изо рта пахнет мочой (foetor uraemicus).
3. На коже выделяется в виде соли мочевина.
4. Интоксикация ДЦ ведет к дыханию Чейн-Стокса, которое может перейти в ацидотическое предагональное дыхание Кусмауля, появляется грубый скрипучий кашель (называют "похоронный скрип"). И чтобы этого Вам не слышать - необходимо хорошо знать этиологию, патогенез, клинику, диагностику и своевременное лечение заболеваний почек. И если в этой благородной и сложной задаче Вам хотя бы немного поможет сегодняшняя лекция - значит какой-то вклад в борьбе за здоровье человека есть и нашей кафедры.
В настоящее время успешно проводится пересадка почки (ленинская премия академика Ю.Н.Лопухин, профессор Лопаткин). Имеются методы консервации, обмен между Ленинградом и Москвой, Евротрансплантант.
Нефротический синдром. Почечная недостаточность может быть следствием так называемого нефротического синдрома, который может быть следствием:
1) первичных заболеваний почек: гломерулонефрит - воспаление клубочков почек, амилоидоз -дистрофические изменения в канальцах, острый и хронический пиелонефрит, опухоли почек, нефропатии беременных.
2) вторичные заболевания - сифилис, системная красная волчанка, ожоговая болезнь, сахарный диабет, капиллярный гломерулонефрит или болезньнь Киммельстиля-Уилсона, заболевания крови - лейкозы, проявляется нефротический синдром массивной протеинурией и как следствие этого - гипопротеинемия > снижение онкотического давления крови, выход жидкости в ткани > развитие отеков.
Механизмы фильтрации. В настоящее время установлено,что фильтрация и гидростатическое давление активно регулируется юкстагломерулярным аппаратом (ЮГА), открытым учеными Юка и Пикелинг. Клетки этого аппарата являются 1) рецепторами ЮГА и 2) его эффекторами. Они обладают способностью выделять ренин. Количество выделяемого ренина зависит от натяжения мембраны оболочки клетки, а это зависит от кровяного давления в клубочках почек. Ренин сам не активен, он влияет на α2-глобулин (ангиотензиноген) - отщепляет пептид из 13 аминокислот - ангиотензин-I, который под действием находящейся в крови дипептидкарбоксипептидазы превращается в ангиотензин II (отщепляется еще 3 аминокислоты).
Установлено, что ренин выделяется в виде гранул при напряжении мембраны клеточной оболочки вследствие падения давления крови в клубочках. У человека при поражении задней доли гипофиза и прекращении выделения АДГ диурез может достигать теоретически максимальных величин. Это объясняется тем, что АДГ способствует обратному всасыванию воды из канальцев в кровь. В отсутствие этого гормона совершенно прекращается активная реабсорбция воды в дистальном сегменте петли Генле - диурез = 17 см3/мин = 25 л/сутки. Возникает несахарный диабет.
Вирус гриппа, РНК-нуклеокапсид, суперкапсида, алгезины и АГ вируса: гемагглютинин и нейраминедаза; виды: А1, А2, В, С и серотипы; антигенный дрейф, интерферонное действие, Т-киллеры и клеточная цитотоксичность.
 Репродуктивный цикл вируса гриппа, формирование ранних и поздних вирусных белков в клетке хозяина, сборка нуклеокапсида; продукция интерферонов, внутриядерных трансляцию-транскрипцию ингибирующих протеинов, нуклеаз; вирусологическим: РТГА при идентификации вида, серологическим: РПГА, ИФА, а также РИФ и ПЦР; воздушно-капельный путь, внутриклеточная инфекция, роль цитотоксических мех-мов иммунной системы, осложнения: оппортунистическая инфекция.
Репродуктивный цикл вируса гриппа, формирование ранних и поздних вирусных белков в клетке хозяина, сборка нуклеокапсида; продукция интерферонов, внутриядерных трансляцию-транскрипцию ингибирующих протеинов, нуклеаз; вирусологическим: РТГА при идентификации вида, серологическим: РПГА, ИФА, а также РИФ и ПЦР; воздушно-капельный путь, внутриклеточная инфекция, роль цитотоксических мех-мов иммунной системы, осложнения: оппортунистическая инфекция.

Репродуктивный цикл ВИЧ, формирование ранних и поздних вирусных белков в клетке хозяина, сборка нуклеокапсида; продукция интерферонов, внутриядерных трансляцию-транскрипцию ингибирующих протеинов, нуклеаз; серологическим: РПГА, ИФА, а также РИФ и ПЦР; половой и парентеральный путь, внутриклеточная инфекция, роль цитотоксических мех-мов иммунной системы, осложнения: оппортунистическая инфекция, активация латентных вирусов, злокач. новообразования.

Репродуктивный цикл вируса гепатита В, формирование ранних и поздних вирусных белков в клетке хозяина, сборка нуклеокапсида; продукция интерферонов, внутриядерных трансляцию-транскрипцию ингибирующих протеинов, нуклеаз; серологическим: РПГА, ИФА, а также ПЦР; половой и парентеральный путь, внутриклеточная инфекция, роль цитотоксических мех-мов иммунной системы, осложнения: острая печёночная недостаточность, цирроз, оппортунистическая инфекция.

3.37 Препарат «Псевдомицелий в мазке со слизистой».
В мазке материала от больного на фоне элементов слизистой оболочки при микроскопическом методе исслед-я определяются грам+ дрожжеподобные клетки с нитевидными элементами псевдомицелия, культуральный метод с использованием селективных сред, б/х идентификация; оппортунистические заболевания полости рта, ЖКТ, др. органов при дисбиозах или иммунодефицитах.
3.38 Препарат «Колонии с пигментами».
Бак. метод, получение изолированных колоний на простой плотной среде; колонии с белым и розовым пигментами, варианты R и S, посев на селективные и диф.-диагн. среды, б/х и серолог. идентификация; 1, 2, 3 этапы.
3.39 Препарат «Колонии стафилококка на кровяном агаре».
Бак. метод, получение изолированных колоний на плотной универсальной среде; колонии с белым пигментом – вариант «S. albus», без гемолиза; посев на селективную среду ЖСА; б/х идентификация, фаготипирование, определение чувствительности к антибиотикам.
3.40 определение лецитиназной активности у хлоридум перфингерс: бак метод, изучение факторов вирулентности, желточный мясо-пептонный агар, вокруг выросших перфиненсов при посеве видны бляшки венчик и среда помутнела в виду расщепл лецитина, культивирование в усл анаэробов на средах, культуральные св-ва вирулентные биолог ический метод, хлоридум перфингерс, новий,гистолицис,септикум-возбуд газовой гангрены
 3.41 Препарат «Цитратная плазма».
3.41 Препарат «Цитратная плазма».
Бак. метод, идентификация по б/х св-вам: культура коагулирует цитратную плазму крови, следовательно, относится к коагулазо+ группе; б/х идентификация и фаготипирование; коагулаза, анаэробная ферментая маннита, серотип, резистентность к новобиоцину.

3.42 Препарат «Дисковая антибиотикограмма, посев чистой культуры стафилококка».
Бак. метод, диффузионный способ определения чувствительности к антибиотикам с дисками на плотной среде АГВ; зоны торможения роста культуры стафилококка вокруг дисков; культура с пигментом желтоватого цвета, мягкой консистенции; для подтверждения диагноза провести идентификацию по б/х и серолог. св-вам, фаготипирование; при инфекц. болезнях обычно назначают монотерапию антибиотиком, к которому наиболее чувствителен данный возбудитель, при оппортунистических – применяют комбинированную и ступенчатую терапию, при выборе антибиотика руководствуются вначале результатами видовой идентификации, а затем – результатами определения чувствительности и, при необходимости, вносят коррекции в лечение.

3.43 Препарат «Бета-гемолиз».
Бак. метод, получение изолированных колоний на плотной универсальной среде; бета-гемолиз вокруг колонии; б/х и серолог. идентификация; полный и частичный гемолиз на кровяном агаре.

3.44 Препарат «Бета-гемолитический стрептококк на кровяном агаре».
Бак. метод, получение изолированных колоний на плотной универсальной среде; бета-гемолиз вокруг колонии; б/х и серолог. идентификация; полный и частичный гемолиз на кровяном агаре.
3.45 Препарат «Альфа-гемолитический стрептококк на кровяном агаре».
Бак. метод, получение изолированных колоний на плотной универсальной среде; альфа-гемолиз вокруг колонии; б/х и серолог. идентификация; полный и частичный гемолиз на кровяном агаре.
3.46 Препарат «Колонии биотипа «mitis» на теллуритовом агаре».
Бак. метод; получение изолированных колоний на плотной селективной среде; S-колонии; окраска по Нейссеру, б/х идентификация, определение токсигенности; лизогения и лизогенная конверсия при участии умеренного бактериофага.

3.47 Препарат «Колонии микобактерий на яичной среде».
Бак. метод; получение изолированных колоний на плотной оптимальной среде; колонии с жёлтым пигментом – вариант R; б/х идентификация, определение чувствительности к антибиотикам; производные ПАСК, стрептомицин, аминогликозиды, рифампицин, фторхинолоны.

3.48 Препарат «Колонии микобактерий на среде Левенштейна-Йенсена».
Бак. метод; получение изолированных колоний на плотной селективной среде во флаконе; колонии с жёлтым пигментом – вариант R; б/х идентификация, определение чувствительности к антибиотикам.

3.49 Препарат «Колонии бацилл на кровяном агаре».
Бак. метод, получение изолированных колоний на плотной универсальной среде; R-колонии с бета-гемолизом; окраска по Ожешко, б/х идентификация; бацилла сибирской язвы.

3.50 Препарат «Слизистые колонии на питательной среде».
Бак. метод, получение изолированных колоний на плотной питательной среде; слизистые колонии капсулообразующих бактерий; микроскопия при окраске по Бури-Гинсу, б/х идентификация; капсула и слизистый слой обуславливают адгезивные и протективные св-ва бактерий, капсульные АГ.

3.51 Препарат «Лактозопозитивные колонии на среде Эндо».
Бак. метод, получение изолированных колоний на плотной диф.-диагн. среде с лактозой; лак+ колонии; серолог. идентификация с О-специфическими агглютинирующими сыв-ками; трансдукция – перенос ген. инф-ции от клетки донора в клетку реципиента с помощью умеренного фага.
3.52 Препарат «Лактозопозитивные колонии на среде Эндо, сливной рост».
Бак. метод, получение изолированных колоний на плотной диф.-диагн. среде с лактозой; лак+ колонии; серолог. идентификация с О-специфическими агглютинирующими сыв-ками; энтеропатогенные, -инвазивные, -токсигенные и т. п., по структуре О-АГ.

3.53 Препарат «Лактозопозитивные колонии на среде Плоскирева».
Бак. метод, получение изолированных колоний на плотной диф.-диагн. среде с лактозой; лак+ колонии; серолог. идентификация с О-специфическими агглютинирующими сыв-ками; энтеропатогенные, -инвазивные, -токсигенные и т. п., по структуре О-АГ.

3.54 Препарат «Тест-системе API E».
Бак. метод, идентификация по б/х св-вам в API Entero: культура ферментирует глюкозу,
но не лактозу, даёт положительную пробу на индол, но не на сероводород,
следовательно, относится к роду шигелл; серолог. идентификация на стекле с моно- и
полирецепторными сыв-ками; биовары и серотипы.
Вирус гриппа, РНК-нуклеокапсид, суперкапсида, алгезины и АГ вируса: гемагглютинин и нейраминедаза; виды: А1, А2, В, С и серотипы; антигенный дрейф, интерферонное действие, Т-киллеры и клеточная цитотоксичность.
 Репродуктивный цикл вируса гриппа, формирование ранних и поздних вирусных белков в клетке хозяина, сборка нуклеокапсида; продукция интерферонов, внутриядерных трансляцию-транскрипцию ингибирующих протеинов, нуклеаз; вирусологическим: РТГА при идентификации вида, серологическим: РПГА, ИФА, а также РИФ и ПЦР; воздушно-капельный путь, внутриклеточная инфекция, роль цитотоксических мех-мов иммунной системы, осложнения: оппортунистическая инфекция.
Репродуктивный цикл вируса гриппа, формирование ранних и поздних вирусных белков в клетке хозяина, сборка нуклеокапсида; продукция интерферонов, внутриядерных трансляцию-транскрипцию ингибирующих протеинов, нуклеаз; вирусологическим: РТГА при идентификации вида, серологическим: РПГА, ИФА, а также РИФ и ПЦР; воздушно-капельный путь, внутриклеточная инфекция, роль цитотоксических мех-мов иммунной системы, осложнения: оппортунистическая инфекция.

Репродуктивный цикл ВИЧ, формирование ранних и поздних вирусных белков в клетке хозяина, сборка нуклеокапсида; продукция интерферонов, внутриядерных трансляцию-транскрипцию ингибирующих протеинов, нуклеаз; серологическим: РПГА, ИФА, а также РИФ и ПЦР; половой и парентеральный путь, внутриклеточная инфекция, роль цитотоксических мех-мов иммунной системы, осложнения: оппортунистическая инфекция, активация латентных вирусов, злокач. новообразования.

Репродуктивный цикл вируса гепатита В, формирование ранних и поздних вирусных белков в клетке хозяина, сборка нуклеокапсида; продукция интерферонов, внутриядерных трансляцию-транскрипцию ингибирующих протеинов, нуклеаз; серологическим: РПГА, ИФА, а также ПЦР; половой и парентеральный путь, внутриклеточная инфекция, роль цитотоксических мех-мов иммунной системы, осложнения: острая печёночная недостаточность, цирроз, оппортунистическая инфекция.

3.37 Препарат «Псевдомицелий в мазке со слизистой».
В мазке материала от больного на фоне элементов слизистой оболочки при микроскопическом методе исслед-я определяются грам+ дрожжеподобные клетки с нитевидными элементами псевдомицелия, культуральный метод с использованием селективных сред, б/х идентификация; оппортунистические заболевания полости рта, ЖКТ, др. органов при дисбиозах или иммунодефицитах.

3.38 Препарат «Колонии с пигментами».
Бак. метод, получение изолированных колоний на простой плотной среде; колонии с белым и розовым пигментами, варианты R и S, посев на селективные и диф.-диагн. среды, б/х и серолог. идентификация; 1, 2, 3 этапы.

3.39 Препарат «Колонии стафилококка на кровяном агаре».
Бак. метод, получение изолированных колоний на плотной универсальной среде; колонии с белым пигментом – вариант «S. albus», без гемолиза; посев на селективную среду ЖСА; б/х идентификация, фаготипирование, определение чувствительности к антибиотикам.

3.40 определение лецитиназной активности у хлоридум перфингерс: бак метод, изучение факторов вирулентности, желточный мясо-пептонный агар, вокруг выросших перфиненсов при посеве видны бляшки венчик и среда помутнела в виду расщепл лецитина, культивирование в усл анаэробов на средах, культуральные св-ва вирулентные биолог ический метод, хлоридум перфингерс, новий,гистолицис,септикум-возбуд газовой гангрены
 3.41 Препарат «Цитратная плазма».
3.41 Препарат «Цитратная плазма».
Бак. метод, идентификация по б/х св-вам: культура коагулирует цитратную плазму крови, следовательно, относится к коагулазо+ группе; б/х идентификация и фаготипирование; коагулаза, анаэробная ферментая маннита, серотип, резистентность к новобиоцину.

3.42 Препарат «Дисковая антибиотикограмма, посев чистой культуры стафилококка».
Бак. метод, диффузионный способ определения чувствительности к антибиотикам с дисками на плотной среде АГВ; зоны торможения роста культуры стафилококка вокруг дисков; культура с пигментом желтоватого цвета, мягкой консистенции; для подтверждения диагноза провести идентификацию по б/х и серолог. св-вам, фаготипирование; при инфекц. болезнях обычно назначают монотерапию антибиотиком, к которому наиболее чувствителен данный возбудитель, при оппортунистических – применяют комбинированную и ступенчатую терапию, при выборе антибиотика руководствуются вначале результатами видовой идентификации, а затем – результатами определения чувствительности и, при необходимости, вносят коррекции в лечение.

3.43 Препарат «Бета-гемолиз».
Бак. метод, получение изолированных колоний на плотной универсальной среде; бета-гемолиз вокруг колонии; б/х и серолог. идентификация; полный и частичный гемолиз на кровяном агаре.

3.44 Препарат «Бета-гемолитический стрептококк на кровяном агаре».
Бак. метод, получение изолированных колоний на плотной универсальной среде; бета-гемолиз вокруг колонии; б/х и серолог. идентификация; полный и частичный гемолиз на кровяном агаре.

3.45 Препарат «Альфа-гемолитический стрептококк на кровяном агаре».
Бак. метод, получение изолированных колоний на плотной универсальной среде; альфа-гемолиз вокруг колонии; б/х и серолог. идентификация; полный и частичный гемолиз на кровяном агаре.

3.46 Препарат «Колонии биотипа «mitis» на теллуритовом агаре».
Бак. метод; получение изолированных колоний на плотной селективной среде; S-колонии; окраска по Нейссеру, б/х идентификация, определение токсигенности; лизогения и лизогенная конверсия при участии умеренного бактериофага.

3.47 Препарат «Колонии микобактерий на яичной среде».
Бак. метод; получение изолированных колоний на плотной оптимальной среде; колонии с жёлтым пигментом – вариант R; б/х идентификация, определение чувствительности к антибиотикам; производные ПАСК, стрептомицин, аминогликозиды, рифампицин, фторхинолоны.

3.48 Препарат «Колонии микобактерий на среде Левенштейна-Йенсена».
Бак. метод; получение изолированных колоний на плотной селективной среде во флаконе; колонии с жёлтым пигментом – вариант R; б/х идентификация, определение чувствительности к антибиотикам.

3.49 Препарат «Колонии бацилл на кровяном агаре».
Бак. метод, получение изолированных колоний на плотной универсальной среде; R-колонии с бета-гемолизом; окраска по Ожешко, б/х идентификация; бацилла сибирской язвы.

3.50 Препарат «Слизистые колонии на питательной среде».
Бак. метод, получение изолированных колоний на плотной питательной среде; слизистые колонии капсулообразующих бактерий; микроскопия при окраске по Бури-Гинсу, б/х идентификация; капсула и слизистый слой обуславливают адгезивные и протективные св-ва бактерий, капсульные АГ.

3.51 Препарат «Лактозопозитивные колонии на среде Эндо».
Бак. метод, получение изолированных колоний на плотной диф.-диагн. среде с лактозой; лак+ колонии; серолог. идентификация с О-специфическими агглютинирующими сыв-ками; трансдукция – перенос ген. инф-ции от клетки донора в клетку реципиента с помощью умеренного фага.

3.52 Препарат «Лактозопозитивные колонии на среде Эндо, сливной рост».
Бак. метод, получение изолированных колоний на плотной диф.-диагн. среде с лактозой; лак+ колонии; серолог. идентификация с О-специфическими агглютинирующими сыв-ками; энтеропатогенные, -инвазивные, -токсигенные и т. п., по структуре О-АГ.

3.53 Препарат «Лактозопозитивные колонии на среде Плоскирева».
Бак. метод, получение изолированных колоний на плотной диф.-диагн. среде с лактозой; лак+ колонии; серолог. идентификация с О-специфическими агглютинирующими сыв-ками; энтеропатогенные, -инвазивные, -токсигенные и т. п., по структуре О-АГ.

3.54 Препарат «Тест-системе API E».
Бак. метод, идентификация по б/х св-вам в API Entero: культура ферментирует глюкозу,
но не лактозу, даёт положительную пробу на индол, но не на сероводород,
следовательно, относится к роду шигелл; серолог. идентификация на стекле с моно- и
полирецепторными сыв-ками; биовары и серотипы.
1. Из очаговых расстройств при болезни Альцгеймера обязательными являются:
а) афазия
б) апраксия
в) агнозия
г) все перечисленное
д) ничего из перечисленного
2. При болезни Альцгеймера выявляется:
а) аграфия
б) алексия
в) акалькулия
г) все перечисленное
д) ничего из перечисленного
3. Депрессии при болезни Альцгеймера наблюдаются:
а ) в начальной стадии
б) в исходной стадии
в) в развернутой стадии
г) во всех стадиях
4. Для болезни Пика характерно:
а) быстрое поражение высших форма интеллекта
б) быстрое исчезновение критики
в) сравнительно меньше на первых этапах болезни страдает память
г) все перечисленное
д) ничего из перечисленного
5. Болезнь Пика следует дифференцировать:
а) с прогрессивным параличом
б) с болезнью Альцгеймера
в) с лейкоэнцефалопатией
г) со всем перечисленным
6. Особенностями деменции в начальной стадии прогрессивного паралича являются:
а) рано и резко нарушенная критика к своему состоянию
б) потеря понимания межличностных отношений
в) утрата памяти и приобретенных знаний в меньшей степени чем высших интеллектуальных функций
г) все перечисленное
д) ничего их перечисленного
7. Тотальная деменция характерна для:
а) церебрального атеросклероза
б) эпилепсии
в) прогрессивного паралича
г) шизофрении
д) ничего из перечисленного
8. Тотальная деменция характерна для:
а) инволюционных психозов
б) сифилиса мозга
в) болезни Пика
г) посттравматической энцефалопатии
д) всего из перечисленного
9. Лакунарная деменция не характерна для:
а) болезни Альцгеймера
б) сифилиса мозга
в) эпилепсии
г) церебрального атеросклероза
д) всего перечисленного
10. Концентрическое слабоумие развивается при:
а) шизофрении
б) эпилепсии
в) прогрессивном параличе
г) болезни Пика
д) болезни Альцгеймера
11. При тотальной деменции наблюдается:
а) распад ядра личности
б) снижение памяти
в) снижение интеллекта
г) все перечисленное
д) ничего из перечисленного
12. Для болезни Альцгеймера характерно:
а) нейрофибриллярные сплетения
б) амилоидные бляшки
в) повышенное содержание алюминия в мозге
г ) все перечисленное
д) ничего из перечисленного
13. Симптом «стоячих оборотов» чаще всего выявляется при:
а) шизофрении
б) болезни Пика
в) болезни Альцгеймера
г) эпилепсии
д) мультиинфарктной деменции
14. Способность к письму при сосудистой деменции:
а) нарушается в начале заболевания в виде повторов и пропусков букв
б) длительное время не нарушается
в) характерно изменение почерка без грубых ошибок орфографии
г) быстро развивается аграфия
д) нет верного ответа
15. Для течения сосудистой деменции характерно:
а) неуклонное прогрессирование
б) волнообразный характер прогрессирования
в) быстрое наступление стационарного состояния
г) отсутствие компенсаторных возможностей
д) нет верного ответа
16. Для сосудистой деменции характерно:
а) благодушие с говорливостью
б) расторможенность влечений
в) слабодушие с эмоциональной лабильностью
г) эмоциональная холодность
д) все неверно
|
|
|
|
|
Дата добавления: 2015-06-27; Просмотров: 843; Нарушение авторских прав?; Мы поможем в написании вашей работы!